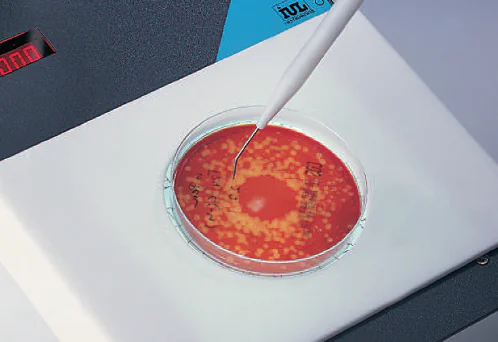

Colony Counters: Manual Colony Counter – DOT
Choose from two manual colony counters models
Description
PRODUCT OVERVIEW
Neutec understands that the researcher’s task to count colonies manually can be both time-consuming and challenging. To facilitate this process, Neutec offers IUL’s line of bacterial colony counters. These include IUL’s manual colony counter so that the bacterial colony counting process is both streamlined and accelerated, due to the implementation of LED illumination and a high-grade magnifying lens. This colony counter proves indispensable for any microbiology lab engaged in colony enumeration. These manual colony counters enable a straightforward bacterial colony counting process: Petri plates are placed within the colony counter where they are appropriately lit and magnified. Operators have the ability to mark recognized colonies using a specially designed marker, all while a digital display provides a live tally of the count. Additionally, a feature that performs direct colony counts utilizing a stainless pointer is also available.
SYSTEM HIGHLIGHTS
High Quality Magnification: IUL’s DOT Manual Bacterial Colony Counter has a large 200 mm diameter lens with a DINx2 magnification power.
Pointer Technology: Colonies are counted by directly touching these with a pointer or by marking them on the Petri dish with a felt tip pen.
Adapted For Any Size Plate: Multiple adapters are available 60 mm, 70 mm, 80 mm, 90 mm,100 mm, 120 mm, and 150 mm.
Send Colony Counts to PC Applications Through USB: Colony counts can be sent to PC applications such as a spreadsheet. IUL’s colony counters send the results using standard PC keyboard keystrokes.
Lighting Scalable Intensities: Bottom light, 4 selectable intensities, On/Off switching powered from the instrument. Upper light (depending of the glass magnifier ordered), On/Off switching powered from the instrument.
TECHNICAL DATA
Colony Counter: 4 digits, 9 mm LED-Display. Maximum count 9999
Inputs: Clickable permanent marker/ Stainless contact pointer (optional).
Outputs: USB Human Interface Device (HID) emulating standard PC keyboard output receivable by PC running keyboard compatible applications (Microsoft Windows ®).
USB Virtual COM port (VCP) reserved for IUL, S.A. Technical Service purposes.
Upper light power (12V DC, 500mA).
Magnifying glasses: Biconvex, 100/120 mm Ø, 4 Diopters, DIN x 2
Lightning: Bottom light, 4 selectable intensities, On/Off switching powered from the instrument.
Upper light (depending of the glass magnifier ordered), On/Off switching powered from the instrument.
Mains: 100/240 V, 50/60 Hz
Power: 50W
Dimensions (WxDxH):
211x320x335 mm / 8.3×12.6×13.2 in (Cat. No. 90008700)
211x320x395 mm / 8.3×12.6×15.5 in (Cat. No. 90008701)
Weight:
3,2 Kg / 7,0 lb (Cat. No. 90008700)
2,7 Kg / 5,95 lb (Cat. No. 90008701)
ACCESSORIES
| Description | Cat. No. |
| 60 mm centering device | 9000606 |
| 80 mm centering device | 9000608 |
| 100 mm centering device | 9000610 |
| 120 mm centering device | 9000612 |
| 150 mm centering device | 9000615 |
| Mixed grid 1/16 cm2 | 9000613 |
| Mixed reticule 1/9 cm2 | 9000616 |
| Spiral grid | 9000625 |
| Clickable permanent marker | 900011459 |
| Stainless contact pointer | 900011460 |
| Indelible fibre marker (replacement) | 9000687 |
Specifications subject to change without previous notice.